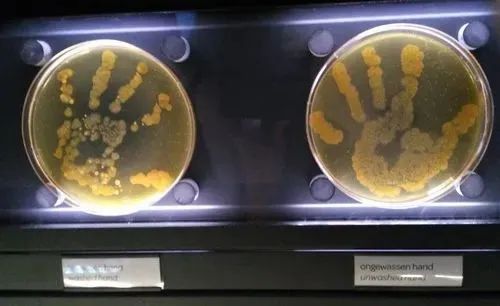
伯努利原理生活应用_听诊器原理生活应用_心脏听诊区及听诊顺序

江西省科技馆筑梦航天主题科学之旅——科学课程报名开始啦!
(接触时间:9:00-16:30开幕日)
02
课程介绍

知道时间

时钟上的双手每分钟和每一秒钟移动,他们的运动代表什么?小时,分钟和第二手之间的联系是什么?孩子们进入了奇妙的时钟世界,并跟随科学老师探索时间的秘密。
了解微生物

显微镜下的微观世界有一个未知的神奇位置。当我们熟悉的事情扩大到一定层次时,它们将产生奇异的效果。也许我们无法用语言解释微生物的奥秘,因此让孩子们通过显微镜探索我们所留下的生命赞美诗。
探索水流通

我们每天都在地球上生活,这支持我们的食物,衣服,住房和运输,并且是人类的故乡。但是您真的了解这个蓝色星球吗?水覆盖了地球区域的70%。地球上的水如何循环?请靠近科学教室,制作一个水流通感官袋,一起探索水流通!
DIY音乐瓶

您知道乐器如何发出各种声音吗?有一种不使用字符串或钥匙的仪器。它只需要一些测试管和一些水,再加上一个小棍子即可击中和击中,并且可以发挥出色的旋律。来与我们一起制作一个美丽而美丽的彩色音乐瓶!
数字建模的初学者:车辆

从街道上的汽车到飞机飞机飞机,人类都有多种环游世界的方式,各种车辆由人类强大的研发和制造行业生产。如今,数字化为传统制造业带来了非凡的变化。您是否想设计各种独特的车辆来实现您的先进想法?来到数字建模课堂,并加速未来!
接近无人机

你知道吗?无人机现在是科学技术领域的热门话题之一,它们被广泛用于飞行,农业,安全等领域。在本课程中,我们将帮助学生了解无人机技术的基本原理和应用通过学习三个部分:无人机理论,模拟器驾驶和实际飞行经验。想探索无人机的神奇世界吗?快来加入我们的班级!
国旗举起平台

国旗是国家和国家的尊严和象征。明亮的五星级红旗是中华人民共和国的国旗。五个辉煌的明星象征着中国共产党各国所有种族的人民的密切团结。国旗升起和瀑布的时间基本上与太阳升起和坠落的时间相同。国旗举起平台是根据皮带轮滚动原则设计的,主要由底座,旗杆开yun体育官网入口登录app,皮带轮提起装置等。
人体结构

人体由多个器官组成,每个器官都起着自己的作用,正是他们的相互合作使我们的人体正常起作用。本课程允许学生通过动手组装理解人体主要器官的位置和功能。
DIY听诊器

当涉及医生时,想到的第一件事是一件白色外套和听诊器。您知道谁发明了如此聪明的乐器吗?您知道使用听诊器的正确方法吗?让我们一起组装听诊器!
电力从何而来

随着技术的发展,没有电力,人们越来越无法做到。当您按开关时,灯打开,屏幕打开,机器正在打开。但是,您是否曾经想过要开始的精力来自哪里?让我们跟随科学老师探索电力的来源。
万花筒

轻轻地转动手中的万花筒,您面前的五颜六色世界也像蝴蝶翼一样改变颜色,光线和阴影。在本课程中,我们将使用光学原理来创建万花筒,并用自己的手创建彩色而美丽的图片。
操纵器

机器人是出现的最早的工业机器人。它可以模仿人手和手臂的某些运动功能,并根据固定程序抓住,携带对象或操作工具。在本课程中,我们使用木屑和塑料扣来制作一个简单的机器人。通过学习原理,我们考虑了未来的机器人。
探索彩虹

在中国神话中,彩虹是五色的努瓦(Nuwa)修复天空的五颜六色的光。在希腊神话中,彩虹女神埃里斯(Eris)是与众神沟通的使者。那么彩虹是如何形成的?让我们一起探索这种“光明礼物”!
3D打印笔小型风车

想拥有一个独特的小风车吗?您可以通过学习使用3D打印笔来做到这一点。来到省级科学技术博物馆,成为一位小型设计师,展示您的奇妙想法!
神奇的潜望镜

潜望镜是一种在潜艇,隧道和坦克中使用的装置,以观察敌人情况。它如何间谍在海洋或海底的地面上?在学习了潜望镜成像的原则之后,我们将用自己的双手制作潜望镜,以感受到侦察活动的紧张和刺激。
魔术镜

魔术镜不仅存在于童话中,而且我们到处都能看到的镜子也有魔术。让我们使用魔镜一起探索光的奥秘!
磁性seesaw

您知道磁性锯的秘密是什么吗?来参加我们的科学课,以了解磁性锯的原理并制作自己的磁性seesaws。
T-Crane博士

建筑工地上的工人如何运输建筑材料?答案是起重机。起重机,也称为起重机,可以垂直抬起和携带重物。在本课程中,我们将跟随T博士组装起重机并学习起重机的机械结构。
3D打印笔自行车

该课程利用3D打印笔的快速成型。通过粘合剂材料,科学教师指导儿童使用3D打印笔来绘制可见且有形的自行车模型,从而创造了一个创意的“科学 +艺术”。
纸使万物

巨石和田顿是中国古代工人智慧的结晶,在各种现代物体中仍然可以看到''和tenon的阴影。在本课程中,我们将了解各种artise和Tenon结构的结构,传统和过程生产过程,并通过折叠弯曲和tenon结构来学习其中所包含的科学知识。
清扫机器人

扫地机器人可以首先将碎屑自动吸收到自己的垃圾箱中,从而完成地面清洁的功能。它的外观帮助我们每天清洁和吸尘工作,为人类的生活带来了极大的便利。现在,我们开始一起制作一个可爱的清扫机器人!
旋转电磁

本课程研究基本的电磁知识,探讨了能量线圈的磁场的变化开元ky888棋牌官方版,了解运动旋转的基本原理,在实践中培养学生的探索精神,并刺激学生对学习科学的兴趣。
记忆中的比例

该量表可能是许多孩子从未见过的称重工具,但陪伴了中国人数千年。看似简单的规模体现了几代工匠的智慧和才能。想知道称重量表的秘密吗?想自己做一个比例吗?快来加入我们!
火箭发射器

火箭目前是人类探索宇宙的重要交通工具之一。飞机和汽车有很多差异,更重要的是如何到达太空。在制作火箭发射器时,让我们一起在这里了解知识!
数字建模的初学者:体系结构

数字建模技术用于各种制造领域。那么数字建模技术可以用于建造房屋吗?当然,来到数字建模教室,创建一个属于您的特殊小房子!
创意编程熊猫飞

本课程学习如何通过“ Xicode编程”软件来控制角色的运动和生成,操作飞行大熊猫以避免攻击怪物,并努力获得更多的分数。快来帮助小熊猫一起比较谁的小熊猫可以获得更多的分数!
钢琴音乐盒

钢琴音乐盒是一种音乐盒。音乐盒也称为音乐盒。这是一种可以播放一些简单音符的乐器。它是一种移动仪器,最初起源于欧洲制表师的创造力。那么他们如何制作精彩的音乐呢?让我们一起学习!
磁性班车

磁性悬浮序列主要使用电磁吸力悬浮液的原理来了解磁体的两个极点,以及“相同的杆相互驱除,不同的杆子相互吸引”,通过制造磁吸力穿梭。
开始使用数字建模:工具

人类改变世界的方式是使用各种工具,这些工具是锤子或科学等概念之类的实体。如今,如果我们想创建不同形状的锤子,我们可以使用数字建模工具快速有效地绘制它。全方位的三维显示可以大大提高效率。您想构建自己的工具吗?快来尝试数字建模类!
人类表面微生物培养
微生物如何增长,需要什么营养?他们需要什么增长条件?让我们制作最简单的微生物绘画 - 人体表面上的微生物!学生可以将准备好的培养基和微生物带回家,请告知他们。
T博士:小赛车俱乐部

你想成为一个小赛车手吗?要成为一名赛车手,您不仅需要具有出色的驾驶技能,而且还需要知道如何设计赛车。在本课程中,我们将学习手推车的基本结构和工作原理,在交流与合作期间制作赛车,并举行激动人心的赛车会议。
对称纸切割

剪纸是中国最珍贵的纸艺术之一。剪纸既是一门美丽的艺术,又包含丰富的数学知识。在本课程中,学生可以学习轴对称和设计的知识,并在他们的脑海中删除对称图形。
创意节目:水果

在本课程中,我们将学习使用“ HUI编程”中的样式编辑器来生成五颜六色的水果,并使用该命令来控制水果从天上掉下来。您将转变为游戏规划师,并操作角色以执行生动有趣的水果拾取游戏!
轮播的光

人类改变世界的方式是使用各种劳动灯笼,这些劳动灯笼以人们在照明灯后在灯罩上追逐和变化的风景的图像命名。让我们一起做一个彩色的左轮手枪,揭开左轮手枪自动旋转的秘密!
风向标

你喜欢风吗?您知道风风对人类有什么好处,又可能造成什么伤害?有什么方法可以准确,直观地确定风的方向?在本课程中开yunapp体育官网入口下载手机版,我们将创建一个简单的天气叶片,并通过科学的思维方式学会观察自然现象。
数字建模的初学者:动物

地球上的生态文明是丰富而丰富多彩的,各种动物生活在我们周围,它们要么危险或可爱。同样,人类不能没有在地球上的公司生活。保护稀有动物是我们一直在努力的方向,使用数字建模,我们可以召唤灭绝的动物并带给我们研究,同时带我们。警告。您想拥有自己的稀有电子宠物吗?来到数字建模课程以完成第一步:绘制它!
吊桥

在生活中,我们可以看到各种桥梁,这给我们带来了便利。您见过悬架桥吗?实际上,它也称为悬挂桥。你可以手工做吗?
时区时钟

“每一英寸的时间都是黄金,黄金不能购买少量时间。”时间流过像水这样的手指的间隙。我们生活中到处都可以看到时钟作为计时工具,但是您知道吗?实际上,不同区域的相应时间也不同。通过研究和生产国际时钟,本课培养了学生的全球思维和珍贵时间的良好习惯。
创意编程熊猫在迷宫中行走

一个可爱的熊猫即将开始寻宝,而神秘的宝藏在危机缠扰的迷宫中隐藏了。为了取得胜利,它需要在每个人的帮助下打破三个困难。本课程使用“智慧编程”软件来学习编程操作和基本原则知识,编写程序并完成熊猫冒险之旅。
3D打印笔的魔术眼镜

想要戴独特的眼镜吗?您可以通过学习使用3D打印笔来做到这一点。来到省级科学技术博物馆,成为一个小型设计师,展示您的奇妙想法。
03
注册入口


单击上面的图片输入注册链接并填写约会注册表。最终注册是否成功,但要遵守注册结果公告(注册后由官方帐户发布)。
04
班级位置

从江西省科学和技术博物馆的南门进入序言大厅,并根据课程介绍中的相应教室参加课程。


